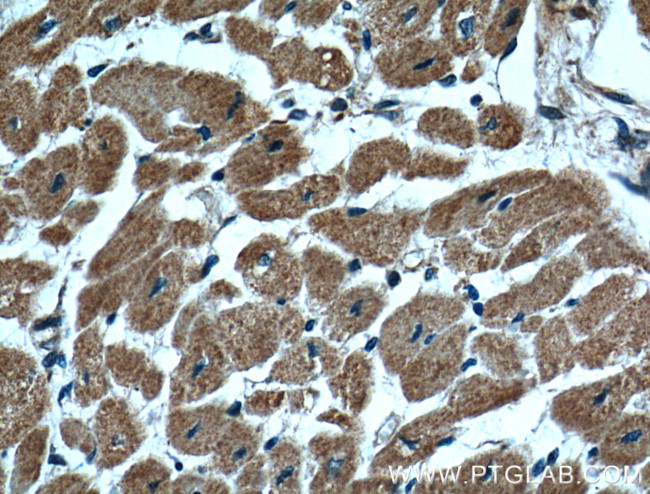
CLPP Antibody in Immunohistochemistry (Paraffin) (IHC (P))
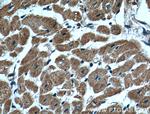
CLPP Antibody in Immunohistochemistry (Paraffin) (IHC (P))

Search
Proteintech
CLPP Monoclonal Antibody (2E1D9)
{{$productOrderCtrl.translations['antibody.pdp.commerceCard.promotion.promotions']}}
{{$productOrderCtrl.translations['antibody.pdp.commerceCard.promotion.viewpromo']}}
{{$productOrderCtrl.translations['antibody.pdp.commerceCard.promotion.promocode']}}: {{promo.promoCode}} {{promo.promoTitle}} {{promo.promoDescription}}. {{$productOrderCtrl.translations['antibody.pdp.commerceCard.promotion.learnmore']}}
产品信息
66271-1-IG
种属反应
已发表种属
宿主/亚型
分类
类型
克隆号
抗原
偶联物
形式
浓度
纯化类型
保存液
内含物
保存条件
运输条件
产品详细信息
Immunogen sequence: MWPGILVGG ARVASCRYPA LGPRLAAHFP AQRPPQRTLQ NGLALQRCLH ATATRALPLI PIVVEQTGRG ERAYDIYSRL LRERIVCVMG PIDDSVASLV IAQLLFLQSE SNKKPIHMYI NSPGGVVTAG LAIYDTMQYI LNPICTWCVG QAASMGSLLL AAGTPGMRHS LPNSRIMIHQ PSGGARGQAT DIAIQAEEIM KLKKQLYNIY AKHTKQSLQV IESAMERDRY MSPMEAQEFG ILDKVLVHPP QDGEDEPTLV QKEPVEAAPA AEPVPAST (1-277 aa encoded by BC002956)
靶标信息
The protein encoded by this gene belongs to the peptidase family S14 and hydrolyzes proteins into small peptides in the presence of ATP and magnesium. The protein is transported into mitochondrial matrix and is associated with the inner mitochondrial membrane.
仅用于科研。不用于诊断过程。未经明确授权不得转售。
生物信息学
蛋白别名: ATP-dependent Clp protease proteolytic subunit, mitochondrial; ATP-dependent protease ClpAP, proteolytic subunit, human; ClpP caseinolytic peptidase ATP-dependent, proteolytic subunit; ClpP caseinolytic peptidase, ATP-dependent, proteolytic subunit homolog; ClpP caseinolytic protease, ATP-dependent, proteolytic subunit homolog; Endopeptidase Clp; putative ATP-dependent Clp protease proteolytic subunit, mitochondrial
基因别名: CLPP; DFNB81; PRLTS3
UniProt ID: (Human) Q16740
Entrez Gene ID: (Human) 8192, (Pig) 100737271